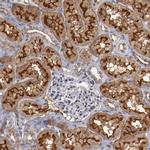
Syntaxin 3 Antibody in Immunohistochemistry (IHC)

Search
Invitrogen
Syntaxin 3 Polyclonal Antibody
{{$productOrderCtrl.translations['antibody.pdp.commerceCard.promotion.promotions']}}
{{$productOrderCtrl.translations['antibody.pdp.commerceCard.promotion.viewpromo']}}
{{$productOrderCtrl.translations['antibody.pdp.commerceCard.promotion.promocode']}}: {{promo.promoCode}} {{promo.promoTitle}} {{promo.promoDescription}}. {{$productOrderCtrl.translations['antibody.pdp.commerceCard.promotion.learnmore']}}
产品信息
PA5-51691
种属反应
宿主/亚型
分类
类型
抗原
偶联物
形式
浓度
规格
纯化类型
保存液
内含物
保存条件
运输条件
RRID
产品详细信息
Immunogen sequence: KQLTQDDDTD AVEIAIDNTA FMDEFFSEIE ETRLNIDKIS EHVEEAKKLY SIILSAPIPE PKTKDDLEQL TTEIKKRANN VRNKLKSMEK HIEEDEVRSS ADLRIRKSQH SVLSRKFVEV MTKYNEAQVD FRERSKGRIQ RQLEITGK
Highest antigen sequence identity to the following orthologs: Mouse - 99%, Rat - 99%.
靶标信息
The gene is a member of the syntaxin family. The encoded protein is targeted to the apical membrane of epithelial cells where it forms clusters and is important in establishing and maintaining polarity necessary for protein trafficking involving vesicle fusion and exocytosis. Alternative splicing results in multiple transcript variants.
仅用于科研。不用于诊断过程。未经明确授权不得转售。
篇参考文献 (0)
生物信息学
蛋白别名: retina-specific SNARE protein; syntaxin 3A; syntaxin 3B; Syntaxin-3; unnamed protein product
基因别名: DIAR12; MVID2; RDMVID; STX3; STX3A
UniProt ID: (Human) Q13277
Entrez Gene ID: (Human) 6809